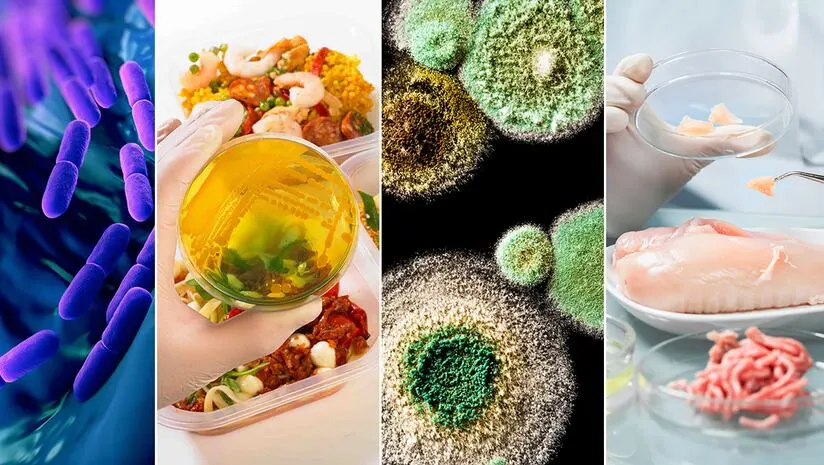
Food safety and hygiene operations

odour control
Industrial Odour: The Hidden Risk Leaders Can’t Ignore

odour control
Odour Extraction: Beyond Fans and Ventilation

odour control

AQOZA delivers advanced clean air solutions for food manufacturing by integrating high-efficiency VOC removal units, industrial air purification systems, and reliable indoor VOC treatment technologies. These scalable and eco-friendly solutions ensure consistent, compliant odour control in food processing environments while protecting product integrity, regulatory compliance, and long-term operational reliability.
Open processing areas allow airborne microbes to contaminate products, increasing recalls, complaints and safety risks.
Cooking and waste handling release VOCs and odours, degrading air quality, hygiene standards and comfort.
Uncontrolled airflow transfers polluted air into packaging zones, increasing cross contamination, downtime and investigation workloads.
Noncompliance with air quality regulations triggers penalties, audit failures, negative publicity and lost brand trust.
AQOZA delivers integrated, energy-efficient clean air and odour control solutions for food processing plants, designed to protect food safety, product quality and regulatory compliance.
Our VOC removal unit captures airborne contaminants at source, protecting products, people, equipment and environments.
High efficiency air purification systems remove microbes, dust and spores from sensitive production environments safely.
Eco friendly odour control technologies neutralise cooking and processing odours while minimising environmental impact significantly.
Indoor VOC treatment systems maintain stable air quality across zones, supporting compliance and product consistency.


Clean controlled air reduces contamination risk and strengthens food safety, quality assurance and audit performance.

Proven systems support regulatory compliance, customer audits, sustainability goals and continuous operational improvement for plants.

Reduced equipment fouling and corrosion lower maintenance costs, unplanned shutdowns and operational risks across facilities.

Scalable solutions support plant expansion, new production lines, higher throughput and evolving regulatory requirements globally.

Have a look at all our success stories.
AQOZA

Your Transaction has failed. Please go back and try again.
Your booking has been confirmed.
if you proceed, you will lose all your personal data.
if you proceed, you will lose all your personal data.